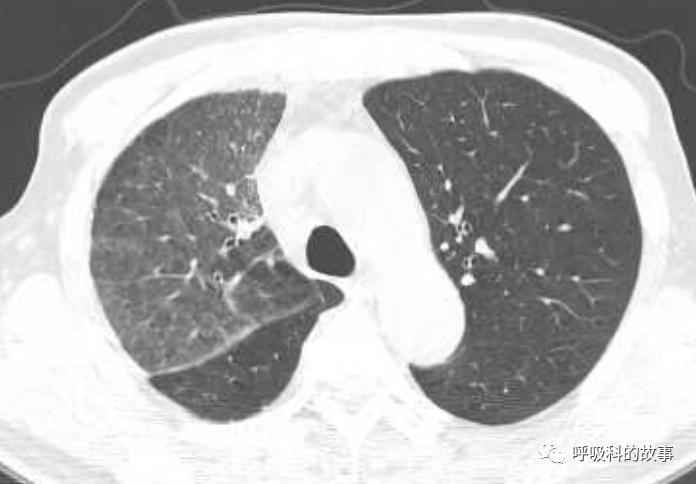
我是如何诊治肺炎的？（4）——如何理解抓住关键信息（2）
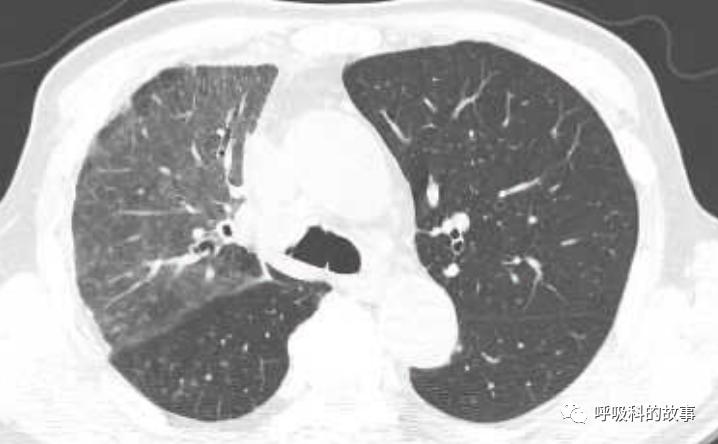
我是如何诊治肺炎的？（4）——如何理解抓住关键信息（2）

接着上一篇病例继续和大家讨论肺炎的诊治,在看这篇文章之前,请看上篇《我是如何诊治肺炎的?(3)——如何理解抓住关键信息(1)》,我想看到这位患者的诊治经过,大多数同道一定会说,做气管镜啊,做肺泡灌洗或者组织活检进行培养,以及mNGS检测吧!是的,终于在治疗近三周无效的情况下,由其他科室转入我科,在入科前做了气管镜检查,报告如下:
隆突尖锐,搏动良好,左主支气管通畅,黏膜充血水肿,左上叶各段开口通畅,黏膜充血水肿,左下叶各段开口通畅,黏膜充血水肿。右主支气管通畅,右上叶各段开口通畅,黏膜充血水肿;右中间支气管通畅,右中叶及右下叶各段开口通畅,黏膜充血水肿。于右上叶行肺泡灌洗。超声所见:超声鞘管及小探头,于右上叶前段各亚段内逐一探查,于右B3b支内探及低回声区,边界不清楚,内部回声不均匀,固定鞘管位置,退出超声探头,进入活检钳行TBLB、毛刷刷检,予送检病理、细胞学、抗酸染色。
最早回报的是肺泡灌洗液mNGS结果,结果好几种病原体,其中一个是一种非常少见的真菌--马尔尼菲蓝状菌。



但问题是这个肺炎是用多种病原体混合感染来解释,还是用单一病原体来解释呢?我们要如何理解mNGS的结果呢?自从mNGS出来之后,这方面的问题就始终在困扰着每个临床医生。从NGS出来的这些病毒有没有意义呢?有多大意义?细菌中肠球菌检测出来,需要不需要治疗?
一方面不能耽误病人的治疗,一方面我们也急切地想知道微生物培养的结果,因此我们先调整治疗方案,将此前的莫西沙星和美罗培南停用,改成了伏立康唑和利奈唑胺治疗,接下来的体温变化图如下:



体温很快恢复正常,而利奈唑胺也在使用五天后停用了,而继续使用的是伏立康唑,培养在气管镜的第四天也出来了,的确是马尔尼菲蓝状菌。

随着体温下降,化验结果也逐渐恢复了正常


虽然接下来的治疗很顺利,但萦绕在我们脑海里的问题是:他怎么会得这种少见病?马尔尼菲蓝状菌以往报道是在艾滋病患者为多,也就是免疫缺陷的病人容易出现。但是这位患者并未发现免疫缺陷的证据,我们如何解释呢?另外他颈部淋巴结肿大能否也用马尔尼菲蓝状菌来解释呢?
这时候,我们要感谢万能的朋友圈,我在朋友圈里发现了一个广西医大的一位研究马尔尼菲蓝状菌的教授,联系上了她,得知感染马尔尼菲蓝状菌的病人有很多体内存在有干扰素抗体,而这种抗体她那里可以测定(而且那个时候估科研不收费)。我立即自已付快递费将标本寄过去,一周后结果回报,这个患者r-干扰素抗体阳性(1:500)。当时这位教授还提醒我,说这样的病人容易合并非结核分枝杆菌感染,要我们小心。
当时我们也曾经考虑给病人做淋巴结活检,但再次遭到患者的拒绝,由于患者体温正常,症状好转,我们也没有坚持。经过了两个多月的伏立康唑治疗,肺部影像基本吸收。

纵隔淋巴结也明显缩小了




到此为止,应该说功德园满,大功告成了吧!可是,患者浅表淋巴结却在继续增大,且伴有明显消瘦,也就在伏立康唑停药的同时,他再次来到我们医院。这一次无论如何是要做淋巴结活检了,病理结果如下:
淋巴结正常结构存在,淋巴窦扩张, 血管内皮增生肿胀,副皮质区增生,可见数灶类上皮样细胞、结节和个别多核巨细胞,浆细胞灶状浸润;灶性可见中性粒细胞微脓肿。表皮、真皮无明显改变,皮下脂肪组织见脂肪坏死 伴大量组织细胞反应(内夹杂泡沫细胞和多核巨细胞)和中性粒细胞小脓肿及肉芽组织增生,累及骨骼肌组织,抗酸染色(+)。
抗酸阳性,是结核吗?为什么之前的T-spot阴性呢?或者是非结核分枝杆菌?还是诺卡菌?还好培养没让我们等太久,培养的结果是:
脓肿分枝杆菌
果然如广西附一院的教授所说,感染马尔尼菲蓝状菌的病人要警惕合并NTM的可能。最后这个病例是肺马尔尼菲蓝状菌感染合并非结核分枝杆菌感染,患者后来口服了莫西沙星+克拉霉素治疗,浅表淋巴结后来逐渐缩小。不过,这其中还有一个小插曲,就是在治疗的过程中,患者发生了一次脑梗塞。原来前面介绍过患者有高血压病史,服用氨氯地平降血压,但是由于克拉霉素和氨氯地平联用,会导致氨氯地平血药浓度增加,导致其血压下降明显,引发了低血压的脑梗塞。
这个病例的确有些曲折,也让我对马尔尼菲蓝状菌感染有了更深层的认识。我们再回头去看一下病例,发现围绕着浅表和纵隔淋巴结肿大这一关键信息,在诊治过程中并没有完全被重视过。虽然最初查体时都已发现浅表淋巴结肿大这个关键信息,但是并没有坚持进行淋巴结活检。另外针对纵隔淋巴结肿大这个关键信息,在最初的诊治过程中没有特别关注,仍然按照普通肺炎进行治疗。其实能引起纵隔淋巴结肿大的感染性疾病不多,最常见的可能是结核,其次是真菌(包括隐球菌和马尔尼菲蓝状菌)。我总结了我院诊断过的7例马尔尼菲蓝状菌感染的病例,发现影像学上纵隔淋巴结肿大是非常常见的表现。


当然,需要鉴别的疾病主要是结核导致淋巴结肿大(见下表),可以发现结核淋巴结肿大多是中央低密度和不均匀低密度区,强化多为环状强化;而马尔尼菲感染的淋巴结肿大多是均匀密度,强化多为均匀强化。

所以如果我们能对这些特征有所了解,那么其实诊断肺马尔尼菲蓝状菌感染并不是什么难事。后来我们又遇到一个肺部结节的患者(如下图):


大家可以发现这个小结节外周有晕征,内部有一小空洞,更重要的是纵隔淋巴结肿大,因此我们马上考虑到肺马尔尼菲蓝状菌感染,进行气管镜检查,做纵隔淋巴结穿刺培养出马尔尼菲蓝状菌。
因此在面对肺炎的时候,需要有针对性地抓取关键信息,同时有针对性的检查才能有效的诊治。